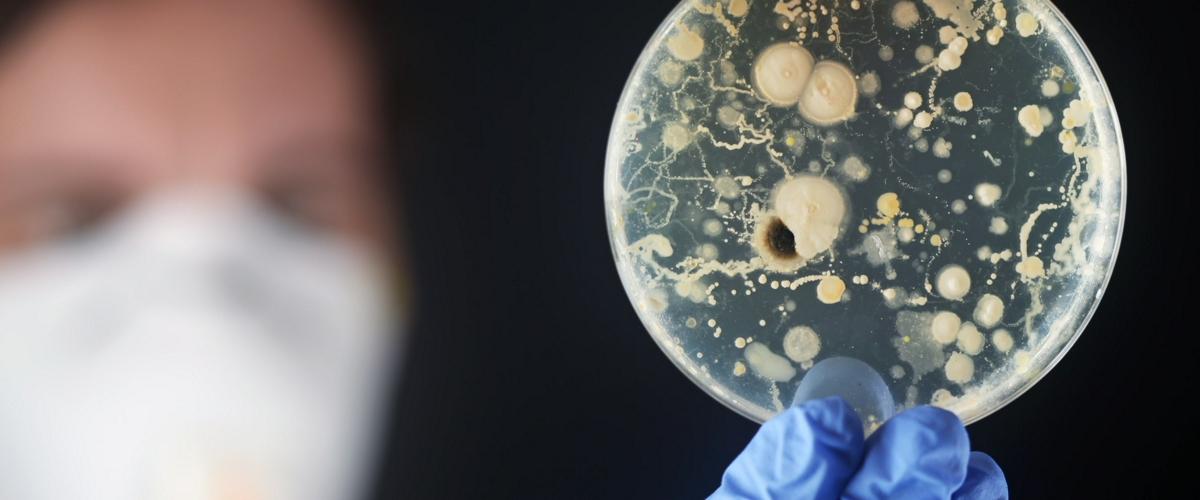
TODO:

Предыдущие исследования показали, что микробиота кишечника, а именно — бактерии желудочно-кишечного тракта — связаны с сердечно-сосудистыми заболеваниями. Микробиота кишечника уникальна у разных людей, однако у пациентов с патологиями сердца и сосудов наблюдаются определенные характерные особенности.
Микробита кишечника состоит из триллионов бактерий, поэтому ученые применили инструменты искусственного интеллекта для идентификации общих паттернов. ИИ проанализировал образцы стула 1000 человек — здоровых и с сердечно-сосудистыми заболеваниями. Результаты опубликованы на сайте Американской кардиологической ассоциации.
Затем ученые классифицировали бактерии.
У людей с сердечно-сосудистыми заболеваниями более многочисленными были бактероиды, бактерии subdoligranulum, клостридии, мегасферы, эубактерии, вейлонеллы, ацидаминокки и листерии.
У здоровых чаще присутствовали типы faecalibacterium, ruminococcus, proteus, lachnospira, brevundimonas, alistipes и neisseria.
«Несмотря на то, что состав микробиоты сильно отличается у разных людей, мы были удивлены точностью предварительных результатов относительно паттернов у пациентов с сердечно-сосудистыми заболеваниями», — подчеркнули авторы.
Вполне возможно, что скоро мы сможем диагностировать эти патологии по обычному лабораторному анализу стула пациентов, добавили они.
Дальнейшие результаты должны улучшить точность диагностики и подтвердить полученные выводы.
Оценкой других микроорганизов, живущих на коже, занимались ученые из Калифорнийского университета. Оказалось, что они могут быть наиболее точным индикатором старения и определять возраст человека с точностью до 4 лет.